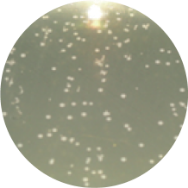
Vaginal remodeling laser_treatment

Expand CO2 laser option
for gynecologic use.
EVERO is an innovative laser, designed vaginal applicator with fractional CO2 laser system as scanner type to fills women’s satisfaction as fundamental solution of vagina. It can remodel with thermal effects of the laser and stimulate collagen regeneration in the soft tissue and discoloration and other undesired skin abnormalities, helping women feel like themselves again.
Laser for Women
Vaginal remodeling and vulval tone improvement to raise the quality of women life.
Quick Treatment
10 mins per 1 session with less pain and side effect. Post procedure, most patients can return to their normal routine with little to no downtime.
Optimized Probe
Vaginal handpiece designed for safe treatment and better result.
Platform mode optional
Select the version based upon your medical field
CO2
Surgical
FRX
Fractional
EVE
Vaginal
Finexel Mono
Finexel Evero
Mode
Scanning Shape

Circle

Standard

Alternate

Random

Scatter
Scanning Shape

Square

Rectangle

Triangle

Circle

Standard

Alternate

Random

Scatter
Thermal stimulation of entire vaginal wall layer
Immediately after treatment, shrinkage of the vaginal skin fibers occurs. In addition, collagen growth is promoted and the vaginal wall becomes resilient and thick. Changed Vaginal structure after treatments makes its whole conditions better.

Before

After
Effect of Laser Treatment Collagen Stimulation
- Vaginal Remodeling
- Vaginal Dryness
- Sexual Dissatisfaction
- Pelvic Organ Prolapse
- Urinary Incontinence
Bacteria Reduction
Vaginitis
Cunnus Pruitus
leucorrhea

Before
Harmful Bacteria
After
Like regular scaling for oral health,
regular Evero treatment for vaginal health
Handpiece
Connector
It can be rotated in a total of 8 stages
and can be rotated up to 360 degrees
Vaginal handpiece
Reflection Mirror (90°, 360°)
Gold Coated Mirror (90° Reflection)
delivers focused heat with strong energy
Handpiece Guide
It makes the same distance between tissue with laser so it guaranty the uniform laser irradiation into tissue to guaranty overall good vaginal tightening result.
Fractional Handpiece

Scanner Type
Surgical Handpiece

F-50mm
- Spot size : 0.2 mm
- Focal Length : 50 mm

F-100mm
- Spot size : 0.4 mm
- Focal Length : 100 mm
Indication
All the indication of Finexel are available.
Especially Evero is used for gynecology field.
Surgical
Condiloma, Labiaplasty, Verruca etc.
Incision
Excision
Vaporization
Coagulation
Fractional
Before & After

Vagina Remodeling
Treatment Procedure
Vaginal Remodeling
Required No Anesthesia
01
Before the treatment Loosen vagina inner wall
02
03
04
05
06
07
Improve Vulva Discoloration
Product Specification
| System | Fractional CO2 Laser |
|---|---|
| Mode | FRX(Fractional) / CO2(Surgical) / EVE (Vaginal) |
| Wavelength | 10600 nm |
| Power (CO2) | 30/40 W |
| Energy (FRX) | 5 ~ 300 mJ |
| Pulse Frequency | 1 ~ 990 Hz |
| Pulse Duration | 50 ~ 2000 us |
| Electrical | 110-120, 220-240VAC, 50/60Hz |
| Dimension | 350(W) x 400(L) x 1000(H) mm |
| Weight | 50 kg |
Quotation and introduction inquiry
We will provide you with detailed information.